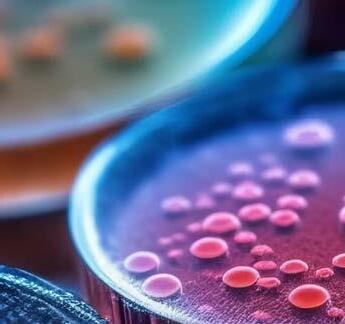

THIS REPORT SHOWS THE UK’S LIFE SCIENCES SECTOR AS VIBRANT, PROGRESSIVE AND SUCCESSFUL. IT IS FORGING NEW PATHS INTO HIGH-IMPACT THERAPEUTIC AREAS AND HIGH-POTENTIAL TYPES OF DRUGS.

It rests on a strong science base and is itself a seedbed and fertiliser for growth and established companies. It outperforms its regional competitors and has made good use of the increased flows of post-pandemic life sciences financing. There is also promise of significant future growth funding through the future deployment of UK pension funds.
However, the sector’s success has reduced the availability of talent, services and space at a time of increased costs and a tightening of today’s funding belt, with the early-stage innovation companies across the nation being hardest hit. Therefore, to maintain the success of the sector, the UK must work effectively together to maximise the number and quality of the national ‘Fit-To-Fund’ SME pipeline.
Through direct, targeted and coordinated action, Medicines Discovery Catapult and its stakeholders must now help early-stage companies across the UK access the skills, enabling technologies and nurturing that they need and for investors to have maximum visibility of what the whole of the UK is producing.
In short, a national Fit-To-Fund activity that will ultimately serve our patients, our pensions and our national productivity.
Professor Chris Molloy Chief Executive Officer Medicines Discovery Catapult
As the CEO of the BioIndustry Association, I have been privileged to witness the remarkable strides the UK biotech sector has made over the past five years.
It has been a journey of innovation, resilience and progress, driven by the dedication and brilliance of our industry players, particularly our SMEs.
Our industry has transformed significantly, capitalising on the strong, sustained flows of international capital, especially post-COVID-19. This transformation has led to the creation of our most diverse and innovation-filled pipeline of drug candidates in history.
At the heart of this sector are SMEs – start-ups and scale-ups – which represent a staggering 70-80% of the businesses in the UK life sciences industry. They are at the forefront of innovation, with the majority of new medicines in the global pipeline originating from their labs. Their agility and cutting-edge research are propelling us forward in oncology, infectious diseases and neurological disorders. Their success is not just a win for the sector but a beacon of hope for patients worldwide.
In 2024, our sector, like most others, continues to face economic headwinds. The 2023 Mansion House Compact promises new sources of capital are on the horizon, but it is up to us as a sector to reach out and build the partnerships needed to secure that capital. This means developing new collaborations across public and private sectors, nurturing talent, making the most of our existing resources and demonstrating what our SMEs can deliver financially and scientifically.
With a laser focus on collaboration, innovation and targeted support, the UK is perfectly positioned to maintain its leadership in the life sciences. Together, we’re not just talking about creating a dynamic, sustainable medicines discovery sector; we’re making it happen for the benefit of patients and our country’s future economic growth.
Here’s to a future filled with possibilities and progress.
Steve Bates OBE Chief Executive Officer BioIndustry Association

For the UK to become a global life science superpower, we must create a conducive environment across all stages of medicine development to support UK-based companies and attract more inward investment.
This means an ecosystem that facilitates the seamless transition of cutting-edge discoveries through the development pipeline, as well as providing a clear route for adoption of these medicines by the NHS and other countries.
This report highlights some of the critical dependencies for companies to fulfil their potential within the UK medicines discovery sector. For the UK to become more internationally competitive and foster homegrown talent, a desire for certainty is cited by companies across different sectors, regardless of their company size or stage of maturity. Certainty can be provided through supportive government policies, such as the right fiscal incentives for investors, be they external venture capitalists or global decisions makers in a multi-national company. Access to a highly skilled workforce, equipment and facilities is also critical to provide companies with the certainty they need to plan, deliver, and grow.
Novel data in this report showcases the vibrant discovery sciences sector we have in the UK, but it also demonstrates the vulnerabilities of the ecosystems to shocks, such as those arising during the pandemic. It is vital that we manage these vulnerabilities, by putting policy levers in place that enable our assets and companies to flourish, and that facilitate collaborations between our world-leading academic science base, agile SMEs and large pharmaceutical companies. If we get this right, the prize is enormous, with the benefits shared by patients, the NHS, the UK R&D base, and the wider UK economy.
Richard Torbett Chief Executive The Association of the British Pharmaceutical IndustryIt has over 6,850 businesses, 70-80% of which are small to medium enterprises (SMEs). Collectively, life sciences companies employ over 300,000 people, generated £108.1bn in turnover in 2021 and account for 35% of all life science start-ups created in Europe since 2012.

Medicines discovery is at the core of the life sciences sector. It advances medical knowledge, drives innovation in identifying potential new medicines and vaccines to treat human disease and prevent ill health, and improves patient care. Medicines discovery is a complex process and is delivered through partnerships.
Its success over the past five years has resulted in a robust national pipeline of valuable assets, with increasing diversity across therapeutic areas and a developing focus on innovative complex medicines. A significant number of new medicines in the global pipeline are discovered by early-stage SMEs and university spin-outs, translating academic research into commercial outputs. Large pharmaceutical companies and SMEs of all sizes play an essential role in the medicines discovery ecosystem, contributing new therapeutic candidates and bringing innovative tools and approaches to the medicines development pipeline.
This year’s State of the Discovery Nation report, delivered by Medicines Discovery Catapult (MDC) in partnership with the Association of the British Pharmaceutical Industry (ABPI) and the BioIndustry Association (BIA), takes stock of the UK medicines discovery ecosystem, identifying today’s challenges and the opportunities ahead. With SMEs, large pharmaceutical companies, venture capitalists, academia, charities and the service sector all playing a role in the medicines discovery process, this report focuses on how the ecosystem as a whole can work together for success.
In addition to analysing available data on the UK discovery and development pipeline, MDC surveyed SMEs with headquarters in the UK, large pharmaceutical companies and Contract Research Organisations (CROs), followed up with in-depth interviews and held a cross-sector stakeholder workshop to explore and discuss the outputs.

UK LIFE SCIENCES AT A GLANCE:
6,850 businesses
Over 300,000 people employed
Generated turnover of £108.1bn in 2021
Although these issues affect many stakeholders, they are exacerbated for early-stage SMEs. These companies are smaller with comparatively fewer resources than more established companies and, therefore, are typically more dependent on gaining access to public and private funding and partnerships to sustain and accelerate their discovery research.
The majority of stakeholders consulted, regardless of size or sector, highlighted challenges in access to sufficient numbers of skilled individuals to drive forward cutting-edge medicines discovery.
This problem was keenly felt by SMEs that are reliant on access to specific technologies, expertise and laboratory space at specific stages of product development to generate the necessary evidence required to unlock future investment.
The medicines discovery pipeline engages a number of interdependent sectors, of which SMEs form a critical part. As a key source of innovation, it is vital that those challenges that disproportionately impact SMEs are addressed. Failure to do so will risk the UK’s future supply of investible companies, curtail input into large pharmaceutical company pipelines and hamper the generation of potential novel therapies that would bring benefit to patients.

For the UK to achieve its ambition to become a global superpower in life sciences and support a strong medicines discovery pipeline, the sector must:
• Foster partnerships with translational experts at the right time to de-risk assets for investment, wherever they are in the UK
• Provide high-quality laboratory facilities and incubator spaces with platform technologies and equipment that are available for companies at all stages of maturity
• Develop capability and capacity that encompass the breadth of skills required to meet today’s research needs, from technical expertise in specialist CROs, multidisciplinary skills within SMEs, venture building for university spin-outs, and increasing demand for data and digital skills at all phases and for all organisations in medicines discovery
• Nurture great scientists and future leaders across a range of skill sets, from scientific translation to management across all sectors in medicines discovery
• Make investible companies visible and funds available, to support the best SMEs and better direct use of private/public initiatives across government agencies, trade associations and investors to co-develop pipelines of high-quality ‘Fit-To-Fund’ companies
Overcoming the challenges highlighted in this report will support the UK’s thriving life sciences sector and secure a rich drug development pipeline to build on its global leadership in life sciences – delivering innovative treatments and investment returns and achieving sustained economic growth.
THE
UK GOVERNMENT HAS MADE CLEAR ITS AMBITIONS FOR THE LIFE SCIENCES SECTOR. THE 2021 LIFE SCIENCES VISION STATES ITS AIM FOR THE UK “TO BE THE WORLD LEADER FOR DEVELOPMENT, TESTING, ACCESS, AND UPTAKE OF NEW AND INNOVATIVE TREATMENTS AND TECHNOLOGIES”.
The Vision outlines what “government, the NHS, regulators, companies, medical research charities, academia and philanthropy must do to create the environment in which industry can grow and succeed in the UK, and patients and the NHS can receive a real benefit”.
The Government’s Science and Technology Framework builds on the Vision by outlining the actions needed to make the UK a science and technology superpower by 2030.


The State of the Discovery Nation report is timely in light of the Government’s Mansion House Reforms, which could unlock up to £75bn of additional investment from pension funds for high-growth businesses, including those in the life sciences.
A pipeline of high-quality companies must be maintained to realise the potential of these funds for the life sciences sector.
Medicines discovery is a complex process involving many scientific disciplines, cuttingedge technologies and methods.
The pre-clinical stage covers target identification, where researchers identify specific molecules or biological targets that are involved in a disease process; lead generation, where potential drug candidates are identified or designed to interact with the target and modulate its activity; lead optimisation, where lead compounds undergo rigorous testing; and optimisation through preclinical studies, which involves in vitro and tissue models, to assess their safety, efficacy and pharmacokinetics. Promising candidates then proceed to the clinical stage, where they are tested in humans to evaluate their safety and effectiveness.
Within the UK life sciences ecosystem, SMEs, large pharmaceutical companies, venture capitalists, academia, government, charities and the service sector all play a key role in the medicines discovery pipeline.
Collectively, UK SMEs and large pharmaceutical companies have an impressive portfolio of valuable assets which are essential to ensure a sustainable pipeline of new, cutting-edge medicines.
This State of the Discovery Nation report examines the UK medicines discovery ecosystem, identifying its current challenges and opportunities.
It is vital that the UK nurtures and supports its best new companies as they navigate the challenging global financial environment. The report includes several suggestions for how different parts of the ecosystem can work together as a whole to secure a sustainable and vibrant medicines discovery pipeline into the future.
To gain a better understanding of the therapeutic focus of drug innovators with UK headquarters, MDC collated and analysed data from GlobalData. The analysis included both SMEs and large pharmaceutical companies and considered therapy area, modality and pipeline stage.
In the study, a ‘large pharmaceutical company’ was identified as a company with over 250 employees. Examples include Allergy Therapeutics, Immunocore and multinational corporations such as GSK and AstraZeneca.

To understand the UK’s SME therapeutic landscape, company-level data was collated from both public and subscription-based sources such as GlobalData and Beauhurst. Data collection encompassed the period from 2020 through to the second half of 2023. An extensive data set was compiled for each organisation, including details on company status, equity, grants, drug pipeline, deals and finances, where available.
Based on these comprehensive sector data, companies were grouped into one of four stages of evolution: seed, venture, growth or established. These stages provide an indicative gauge of the company’s overall progression, referred to as its evolution, rather than pointing to a specific funding round.
Each company’s evolution stage was determined annually based on its data set (see Appendix A). This approach enabled tracking the trajectories of these UK SMEs based on their stage of development, providing an enhanced understanding of the challenges faced and the support required.
Key sector insights were initially identified from responses to an online survey, with 38 responses received from SMEs, large pharmaceutical companies and CROs. These written responses were followed by nine in-depth interviews. These initial findings were used to establish the content of a stakeholder workshop with representation from SMEs, CROs, large pharmaceutical companies, investors, funders, charities and science parks (see Appendix B).
The outcomes of the workshop informed the findings in this report and the subsequent case for action.

Figure 1 illustrates the split of drug assets across discovery and development in the aggregated pipelines of SMEs and large pharmaceutical companies. Assets at the discovery and preclinical stages are grouped under ‘Discovery’, and ‘Development’ comprises drug assets in human clinical trials.
SME pipelines predominantly comprise discovery assets, whereas large pharmaceutical companies tend to focus more on development assets. These findings highlight the complementary roles of SMEs and large pharmaceutical companies within the medicines discovery ecosystem.
Cardiovascular
Other
Respiratory
Gastrointestinal
Immunology
Metabolic Disorders
Central Nervous System
Infectious Disease
Oncology
Figure 2 shows the distribution of active drug assets by therapy area for SMEs with UK headquarters and large pharmaceutical companies.
Oncology is the primary area of focus and constitutes 35% of the SME pipeline and 46% of the large pharmaceutical company pipeline. The category marked ‘Other’ includes various therapy areas such as cardiovascular, musculoskeletal, ophthalmology and dermatology.
Figure 3 illustrates the distribution of drug assets of UK SMEs and large pharmaceutical companies among four molecule types: biologics, small molecules, complex medicines and others.
‘Biologics’, including monoclonal antibodies, gene therapies and recombinant proteins, represent highly innovative therapies. These are anticipated to play an increasingly influential role in routine patient care as advancements in personalised and precision medicine continue.
‘Small molecules’ have traditionally been dominant in the medicines discovery pipeline. However, as depicted in Figure 3, while small molecules remain significant (accounting for 43% of larger companies’ portfolios and 37% for SMEs), biologics have emerged as the most prevalent molecule type in the drug pipeline for both SMEs and large pharmaceutical companies.
Complex medicines,1 including complex APIs (Active Pharmaceutical Ingredients) with a delivery conjugate or complex dosage forms/ formulations, were identified as an emerging area of growth in MDC’s ‘Shaping the UK into an Epicentre for Complex Medicines’ State of the Discovery Nation report in 2021. They constitute 12% of the drug assets in the pipeline for SMEs and 7% for large pharmaceutical companies.
1 The proposed definition of ‘complex medicine’ can be found here.


During the period under scrutiny, approximately 350 therapeutic SMEs were active in the UK. However, the composition of companies fluctuated annually due to the formation of new companies, mergers, acquisitions and businesses ceasing operations.
Figure 4 displays the annual distribution of companies categorised by their evolution stage.
Over half of the companies fell into the seed category, followed by venture (approximately 25% of companies), growth (around 10% of companies) and established (about 5% of companies).
The UK hosts a significant number of seed companies. These companies are typically young, high-risk entities that depend on private capital and grants for survival. Their presence helps inject vibrancy and diversity into the UK’s drug discovery sector, and as such, they are a vital part of the ecosystem.



Figure 5 analyses the core sources of financing that have sustained UK SMEs over the past three and a half years. It considers equity – public and private capital, revenue from licensing deals and / or service provision as well as grants.
2
£3.5bn
The financing of SMEs saw dynamic changes from 2020 to the first half (H1) of 2023. In 2020, companies obtained £1.8bn in financing, driven mainly by public equity and private capital. By 2021, overall financing increased to £3.0bn, £1.2bn above 2020, driven mainly from private capital. This sharp increase is believed to be driven by investor interest in the life sciences sector as a result of the COVID-19 pandemic, coupled with a low-interest rate environment. However, by 2022, due to geopolitical events, higher inflation and higher interest rates, financing fell to £1.7bn, ending c£100m below 2020 levels. Data for H1 2023 suggest that private capital continues to be the primary funding source, with overall funding levels subdued.
Over the course of 2020 and 2022, there was a shift in the mix of financial support for SMEs, leading to a reduction in the amount of financing, which impacted a broad range of companies. The overall reduction in financing has been compounded by the increase in inflation over the period.


Figure 6 illustrates the breakdown of funding across UK SMEs according to their evolution life stage.
Venture and established SMEs witnessed an increase in financing during 2021, followed by a reduction in 2022; however, overall financing remained above 2020 levels, demonstrating investor appetite for these organisations.
In contrast, seed and growth organisations have experienced a decline in funding since 2020. Seed companies, which account for over 50% of UK SMEs, have experienced a small fall in funding year-on-year that has been further eroded by inflation. This decline in funding for this vital sub-segment is likely to have a downstream impact on the wider ecosystem unless greater support for these organisations is provided. Growth organisations, too, have seen a fall in financing due to the challenges of raising public equity, and these organisations have also been impacted by rising inflation rates.
“Biotechs are the engine of innovation in the pharmaceutical industry, and if they aren’t supported through this drought in funding, large pharmaceutical pipelines will dry up.”
Clarivate 2023
“Emerging biopharma companies are responsible for a record 65% of the molecules in the R&D pipeline without a larger company involved, up from less than 50% in 2016 and 34% in 2001.”
IQVIA 2022
The challenges identified by stakeholders can be grouped into three areas:
• INCREASING COSTS
• DIFFICULTY ACCESSING EQUITY INVESTMENT (PUBLIC OR PRIVATE)
• DIFFICULTY ACCESSING PUBLIC (GRANT) FUNDING
• DIFFICULTY RECRUITING AND RETAINING HIGHLY SKILLED, SPECIALIST STAFF
• DIFFICULTY ACCESSING SPECIALIST SKILLS AND EXPERTISE FROM THE CRO SECTOR
• LIMITED AVAILABILITY OF APPROPRIATE LABORATORY SPACE
• LIMITED ACCESS TO SPECIALISED LABORATORY EQUIPMENT OR FACILITIES

1
INCREASING COSTS
The most commonly expressed challenge was increasing costs, including reagents, predictive models, consumables and equipment. Inflation is exacerbating this situation with increasing costs for lab supplies, lab and office rents, and staff salaries.
Supply chain issues and delays in the delivery of equipment also contribute to budgets not stretching as far as they once did. Increasing costs pose a real concern in terms of project completion, regardless of whether funding has been secured.
Steps taken to reduce costs, such as using cheaper materials and not investing in new equipment, can increase operational risks. Budget constraints limit recruitment, further stretching capacity, with recruitment of appropriately skilled staff described by some companies as being out of reach.


2
DIFFICULTY ACCESSING EQUITY INVESTMENT (PUBLIC OR PRIVATE)
Difficulty accessing equity investment was a key challenge impacting seed organisations significantly.
It became increasingly difficult to access funding in late 2022, which continued in 2023. This is potentially a result of investors being less willing to invest in both high-risk organisations and high-risk projects during a period of economic instability resulting from high interest rates and inflation.
There can be hesitance within the investor community to back early-stage companies, given the high-risk nature of the investment and the limited data available, which has led to an increase in qualification requirements, particularly for universities and seed companies. It is essential to have access to high-quality capabilities to de-risk these assets, but investment is required to unlock that access, which has created a vicious circle.
Differences were highlighted between the UK and the US in terms of investor attitudes to early-stage, high-risk organisations. US investors remain more willing to invest in these organisations –and capitalise them fully – compared with investor counterparts in the UK.
3
DIFFICULTY ACCESSING PUBLIC (GRANT) FUNDING
Difficulty accessing public funding was a particular challenge for seed and venture companies.
However, this impact was recognised across all organisations as grants are hugely important to generate initial data and secure follow-on investor funding. This point was echoed by interviewees from large pharmaceutical companies, highlighting that something needs to be done to bridge the gap to allow smaller organisations to develop their portfolios.
There were various difficulties and pain points described:
• Success rates are low, and the quality of applications is high, resulting in exciting projects not obtaining funding
• There is a lack of awareness of available grants
• Some grant schemes are not clear on the amount of available funding
• The time required to write grant applications can be excessive
• There is a wide range of requirements for different grants.
Recruiting and retaining staff remains a key challenge across the organisation types, but is especially challenging for seed and CRO companies.
Experienced staff may be unwilling to take the career or financial risks of moving to a start-up. Where seed and venture organisations recruit graduates or less experienced staff, they may not have the resources to invest in training. For those that do invest in training, there is concern that staff will move on and the investment will be lost.
Interviewees from large pharmaceutical companies have found that those in non-industry-specific roles are in high demand globally, and it is essential for the UK to create, and remain attractive to, highly skilled staff.
states that “of the top thirteen priority skills identified by our survey, eight involve an element of digital or data expertise”. This includes areas such as bioinformatics, computational sciences and physiological monitoring. Such skills are increasing in importance, not only in the life sciences sector but in many sectors across the economy. Candidates with foundational data and digital skills will have a wealth of options to move into a variety of sectors and develop into specialist roles should they wish. There is a need to think outside of purely scientific disciplines in terms of recruitment as some of the skills needed within medicines discovery are sitting in a different ecosystem, for example, analytical, AI, data scientists and engineering. Furthermore, these non-lab-based roles can work anywhere, creating a dynamic market and putting pressure on retention.


OBTAINING ACCESS TO SPECIALIST SKILLS FROM THE CRO SECTOR IS A CHALLENGE, PARTICULARLY FOR THOSE FROM ESTABLISHED AND GROWTH ORGANISATIONS.
2
DIFFICULTY ACCESSING SPECIALIST SKILLS AND EXPERTISE FROM THE CRO SECTOR
Obtaining access to specialist skills from the CRO sector is a challenge, particularly for those from established and growth organisations.
This could be because of a lack of awareness of available services and a need for face-to-face networking opportunities to stimulate commercial collaborations between CROs and medicines discovery companies.
Additionally, some companies will be working with novel high-risk therapeutics which are not yet well understood and therefore the specialised and more novel services required may not yet be on offer. Some seed organisations stated that they can find it challenging to identify CROs offering therapyarea-specific services as the market has shifted towards providing more generic services. This has resulted in higher prices for services that many companies operating in specialist therapy areas cannot afford.
With ‘virtual biotech’ – which is 100% outsourced – now a firmly established business model in a growing sector and changes to R&D tax relief requiring companies to use UK research services suppliers where possible, the ability to outsource R&D activities to UK-based CROs is likely to become ever more important.
The ABPI’s 2023 report states that “of the top thirteen priority skills identified by our survey, eight involve an element of digital or data expertise”.
The limited availability of appropriate laboratory space is a particular challenge for seed, venture and CRO organisations.
The cost of laboratory space has increased significantly, and smaller organisations reported a need to commit to longer-term tenancies to hire laboratory space, which is not always appropriate or viable, especially for companies with insecure, high-cost funding. Shared laboratory spaces allow organisations to access specialised equipment they would not otherwise be able to afford; however, organisations are often reliant on existing relationships to find or afford such shared spaces/equipment.
Many types of organisations provide laboratory space and facilities, including universities, research parks and science parks. The lack of available laboratory space has been recognised and acted upon with multiple new sites under development across the UK. It is also understood that different-sized spaces are required for SMEs at different stages of evolution, and these concepts are being included in future plans. However, this needs to be balanced against the commercial needs of lab facility providers.
Within the UK, there are recognised medicines discovery clusters, and there are multiple benefits to being located within these, including a larger talent pool, proximity to collaborators, incubators, accelerators and regular, well-attended networking events. As such, the clusters subsequently attract further companies and investment. However, to make the very best of public academic funding for invention, and to expand the UK science base beyond these existing clusters, it is essential that spin-out companies outside of these existing regions can access the same skills and expertise. The whole of the UK must be supported to nurture the skills and infrastructure for medicines discovery to thrive.
The whole of the UK must be supported to nurture the skills and infrastructure for medicines discovery to thrive.
LIMITED ACCESS TO SPECIALISED LABORATORY EQUIPMENT OR FACILITIES
Access to specialised lab equipment and facilities was more of a challenge for seed and venture SMEs.
In the earlier stages, companies may not have the funds to buy specialised equipment outright and so rely on rental from other laboratories and access to shared facilities. Moreover, specialist lab facilities can be challenging to access, depending on where the company is located and whether there are any open-access labs nearby.




“Creating a thriving ecosystem is important for early-stage companies to succeed.
With a significant proportion of Kadans’ 2.2m sq. ft UK labs under development dedicated to early-stage companies, we understand the needs of this community. Leveraging our pan-European presence to create knowledge-sharing corridors, plus providing shared and hyperflexible facilities like at our Canary Wharf-based London Innovation Centre, is something early-stage companies benefit hugely from.”
Mairi Dillon Ecosystem Manager UK & Ireland, Kadans
“Babraham Research Campus set up commercial lab space to address the issue of start-up and scale-up companies not being able to access affordable, non-academic lab space in Cambridge.
We provide purpose-built, multi-occupancy buildings and lab spaces for companies as they grow, initially focused on the needs of early-stage companies, providing fully equipped and serviced bio-incubator space with short and part-time lease options, together with campus research grants.”
Kathryn Chapman Director, Science and Entrepreneurship at the Babraham Research Campus

“Early-stage discovery companies need the right space and support to concentrate on efficient technology development and strategy execution.
The Open Access Lab at our Alderley Park campus is the perfect example of that flexible and scalable space, providing state-of-the-art, ready-to-use lab facilities coupled with access to a curated national network of experts and a range of centralised scientific services. Providing everything innovators need for their startup to scale affordably, we’re enabling them to focus on the science that matters.”
Gareth Hampton Senior Lab Manager Science Services, Bruntwood SciTech



Action is required now to address these challenges, as increasing costs, funding difficulties, skills shortages and infrastructure limitations pose barriers to the growth and sustainability of the sector.
The medicines discovery ecosystem is highly interdependent, with academia, SMEs, large pharmaceutical organisations, CROs, investors and funders relying on each other to progress science and deliver patient benefit. For the UK to achieve its ambition of becoming a global superpower in life sciences, the ecosystem must drive UK-wide, active collaboration, coordination and targeted funding and:

Foster partnerships with translational experts, at the right time, to de-risk assets for investment, wherever they are in the UK.
Provide high-quality laboratory facilities and incubator spaces with platform technologies and equipment that are available for companies at all stages of maturity.
Develop capability and capacity that encompass the breadth of skills required to meet today’s research needs, from technical expertise in specialist CROs, multidisciplinary skills within SMEs, venture building for university spin-outs, and increasing demand for data and digital skills at all phases and for all organisations in the medicines discovery pipeline.


Nurture great scientists and future leaders across a range of skill sets, from scientific translation to management across all sectors in medicines discovery.
Make funds available, visible and accessible to support SMEs and more use of private/public initiatives across government agencies, trade associations and investors to co-develop pipelines of high-quality ‘Fit-To-Fund’ companies.
In summary, the challenges highlighted in this report are substantial but not insurmountable. Through open collaboration, using the combined expertise and resources available across the ecosystem and investor community, the UK can foster a dynamic, sustainable medicines discovery sector, delivering patient benefit and economic growth.

Launched in 2019, the Psychiatry Consortium is a unique strategic collaboration of leading medical research charities, eight pharmaceutical companies and contract research organisations to identify and validate novel drug targets to address the unmet therapeutic needs of people living with mental health conditions. It is managed by MDC and supported by Wellcome.
PSYCHIATRY CONSORTIUM AT A GLANCE: £4m in research funding
high-value drug discovery projects Engaged with over 400 research institutions Reviewed and de-risked 139 project proposals
100 introductions between its Partners and global academics
Mental health research is underfunded and has high drug discovery failure rates. The Psychiatry Consortium aims to provide opportunities for funding, collaboration and knowledge exchange to revitalise drug discovery in psychiatry by strengthening collaborations across the sector.
As a collective, the Partners have committed approximately £4m in research funding to deliver up to 10 high-value drug discovery projects, increasing the chance of commercial success in this essential but challenging field.
The Consortium has engaged with over 400 research institutions, reviewed and de-risked 139 project proposals, and facilitated more than 100 introductions between its Partners and global academics.
The Psychiatry Consortium’s model combines the depth of scientific understanding of the researcher with the breadth of drug discovery knowledge of its network of industry partner organisations, allowing it to turn scientific ideas into drug discovery projects.



Transforming innovative ideas into commercially viable businesses.
Supporting the development of early-stage health and life science innovation in the UK.
The Biomedical Catalyst (BMC) is Innovate UK’s flagship grant funding mechanism. It enables small and medium-sized businesses to test and develop innovative health and care solutions across life sciences, including therapeutics, medical devices and digital health.
In 2023, Innovate UK announced the launch of its Biomedical Catalyst Pilot Accelerators, one of three streams of BMC competitions. The programme has been designed to allow “spinouts, start-ups, and entrepreneurial-minded academics to test their ideas and develop concepts with support from key stakeholders from the innovation ecosystem”.
The Pilot Accelerators are focusing on child health, female health, microbiome technologies and neurotech. They have been designed to provide both tailored business and scientific support, including mentoring, networking and funding opportunities, and build on the success of initiatives such as KQ Labs and the Alderley Park Oncology Development Programme.
This access to health and life science expertise is vital to help early-stage companies overcome challenges and increase their chances of commercial success.
At the end of the BMC Pilot Accelerators, companies will have the opportunity to apply for feasibility grant funding of up to £100k at 100% via a closed competition.
Innovate UK’s BMC competition offering also includes:
• Industry-led R&D: Technology agnostic non-diluted grant funding of up to £2m for early-stage companies focusing on developing innovative solutions to address challenges in health and healthcare
• Investor Partnerships: Technology agnostic initiative to support life sciences SMEs through aligning grant funding for R&D development with investment from partnerships with credible investor partners.
A high-level segmentation model was developed to provide further insight into the UK therapeutic SME landscape. The model collated data from public and paid-for sources (such as GlobalData and Beauhurst), including organisation, funding, financial and drug pipeline information.
The model was developed in four phases: creating the initial list of organisations, data gathering, organisation classification by segment and validation.
GlobalData was used to identify UK-headquartered organisations with an active drug asset in their pipeline. These organisations were then matched to company data in Beauhurst to create a comprehensive record for the three years from 1 January 2020 to 30 June 2023. This record included company data, equity fundraising, grants, licence deals and financial information.
Organisations were selected for inclusion in the analysis based on the following criteria:
• They were an SME (defined as having fewer than 250 employees)
• They were active on Companies House
• They had at least one active drug asset on GlobalData
• They were classified by GlobalData as having headquarters in the UK
• They were classified by GlobalData as being a drug innovator
• Sufficient public data existed on their activities to be able to assess them.
The model was independently stress-tested by Beauhurst to ensure completeness and accuracy before detailed analysis.


Established companies are typically older than growth companies and have multiple funding sources and higher cash reserves. They work on multiple assets and typically generate through licensing deals.
Organisations were grouped into one of four evolution life stages: seed, venture, growth or established.
This was achieved by identifying clusters of organisations based on their size, financial maturity and medicines discovery activities.
The key attributes defining the evolution life stages are highlighted in Figure A1. Generally, the key variables increase as organisations progress through the evolution life stages from seed to established. Figure A1.
Overview of evolution life stages of medicines discovery companies.
COMPANY AGE EMPLOYEES
DRUG ASSETS AND PIPELINE
EQUITY FUNDING GRANTS
LICENCE DEALS AND PARTNERSHIPS
FINANCIALS (TURNOVER, CASH)


Seed companies are young, with low numbers of employees, drug assets and limited cash. They are mainly dependent on private capital or grants for financing their R&D activities.
Growth companies are older than venture with multiple funding sources (typically public equity) and higher cash reserves. They employ more and work on multiple assets. They are likely to have partnerships/ licensing deals.
Venture companies are older and have typically secured multiple funding sources and have more employees, drug assets and higher cash reserves. They access private capital or potentially public equity.
• It is recognised that the sector, its organisations and their associated drug assets continuously change. Therefore, the figures presented in this report should be considered a snapshot in time
• Both newly incorporated and stealth organisations are excluded from the analysis because of a lack of data. This exclusion means seed organisations are understated in the study
• The analysis focuses on SMEs (defined as a company having fewer than 250 employees). This means the number of established companies is understated in the study (as they are more likely to have more than 250 FTE)
• The analysis focuses on a specific time period and material financing events may have occurred outside this timeframe.
















SCIENCES SECTOR IS VIBRANT, SUCCESSFUL. IT IS FORGING HIGH-IMPACT THERAPEUTIC HIGH-POTENTIAL TYPES OF DRUGS.

